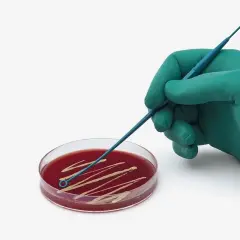
İSOLAB | ÖZE- HIPS Steril 1ul

Tek Kullanımlık ÖZE- HIPS Steril 1ul
Laboratuvar ortamlarında güvenilir ve hijyenik kültür ekimi için tasarlanan HIPS Steril Öze, 10.000 sınıfı steril alanlarda, yüksek kaliteli HIPS (High Impact Polystyrene) malzemeden üretilir. Üretim sonrasında gama ışınları ile yeniden sterilize edilerek, her kullanımda maksimum güvenlik ve streilite sağlar. DNase, RNase ve pirojen içermediğini belgeleyen sertifikası ile birlikte sunulur.
Esnek yapısı sayesinde kültür ekimi sırasında agar yüzeyini korur ve örneklerin homojen şekilde yayılmasını sağlar. Antistatik özellikli hammadde, elektrostatik yüklenmeleri önleyerek kararlı sıvı transferi sunar.Altıgen kesitli ergonomik sap tasarımı, uzun süreli çalışmalarda konforlu kullanım ve yüksek işlem verimliliği sağlar.
Taşıma halkaları yumuşak ve dairesel yapıda olduğundan agar yüzeyine zarar vermez, kesmez veya delmez.Çift taraflı tasarımı sayesinde sapın bir ucundaki sivri uç izole edilmiş kolonilerin tutulması ve taşınması için, diğer uçtaki halka ise ekim işlemleri için kullanılabilir. Farklı renk seçenekleri, öze tipleinin kolay ve hızlı ayırt edilmesini sağlar.
HIPS Steril Öze, üniversite laboratuvarlarından araştırma merkezlerine, kalite kontrol birimlerinden endüstriyel üretim tesislerine kadar geniş kullanım alanına sahiptir. Dayanıklı, ergonomik ve yüksek steriliteye sahip yapısıyla profesyonel laboratuvar çalışmalarında güvenilir bir çözümdür.
1 PKT = 10 adet
Öne Çıkan Özelliler
Laboratuvar ortamlarında güvenilir ve hijyenik kültür ekimi için tasarlanan HIPS Steril Öze, 10.000 sınıfı steril alanlarda, yüksek kaliteli HIPS (High Impact Polystyrene) malzemeden üretilir. Üretim sonrasında gama ışınları ile yeniden sterilize edilerek, her kullanımda maksimum güvenlik ve streilite sağlar. DNase, RNase ve pirojen içermediğini belgeleyen sertifikası ile birlikte sunulur.
Esnek yapısı sayesinde kültür ekimi sırasında agar yüzeyini korur ve örneklerin homojen şekilde yayılmasını sağlar. Antistatik özellikli hammadde, elektrostatik yüklenmeleri önleyerek kararlı sıvı transferi sunar.Altıgen kesitli ergonomik sap tasarımı, uzun süreli çalışmalarda konforlu kullanım ve yüksek işlem verimliliği sağlar.
Taşıma halkaları yumuşak ve dairesel yapıda olduğundan agar yüzeyine zarar vermez, kesmez veya delmez.Çift taraflı tasarımı sayesinde sapın bir ucundaki sivri uç izole edilmiş kolonilerin tutulması ve taşınması için, diğer uçtaki halka ise ekim işlemleri için kullanılabilir. Farklı renk seçenekleri, öze tipleinin kolay ve hızlı ayırt edilmesini sağlar.
HIPS Steril Öze, üniversite laboratuvarlarından araştırma merkezlerine, kalite kontrol birimlerinden endüstriyel üretim tesislerine kadar geniş kullanım alanına sahiptir. Dayanıklı, ergonomik ve yüksek steriliteye sahip yapısıyla profesyonel laboratuvar çalışmalarında güvenilir bir çözümdür.
1 PKT = 10 adet
Öne Çıkan Özelliler
- 10.000 sınıfı steril alanda üretilmiş HIPS malzeme
- Gama ışınları ile ek sterilizasyon
- DNase,RNase ve pirojen içeermediğini belgleleyen sertifika
- Esnek yapı ile agar yüzeyini koruma
- Antistatik hammaddem ile kararlı sıvı transferi
- Altıgen kesitli sap ile ergonomik kullanım
- Çift taraflı tasarım: sivri uç ve halka
- Renk seçenekleri ile kolay ayırt etme
- Yüksek sterilite ve güvenilirlik